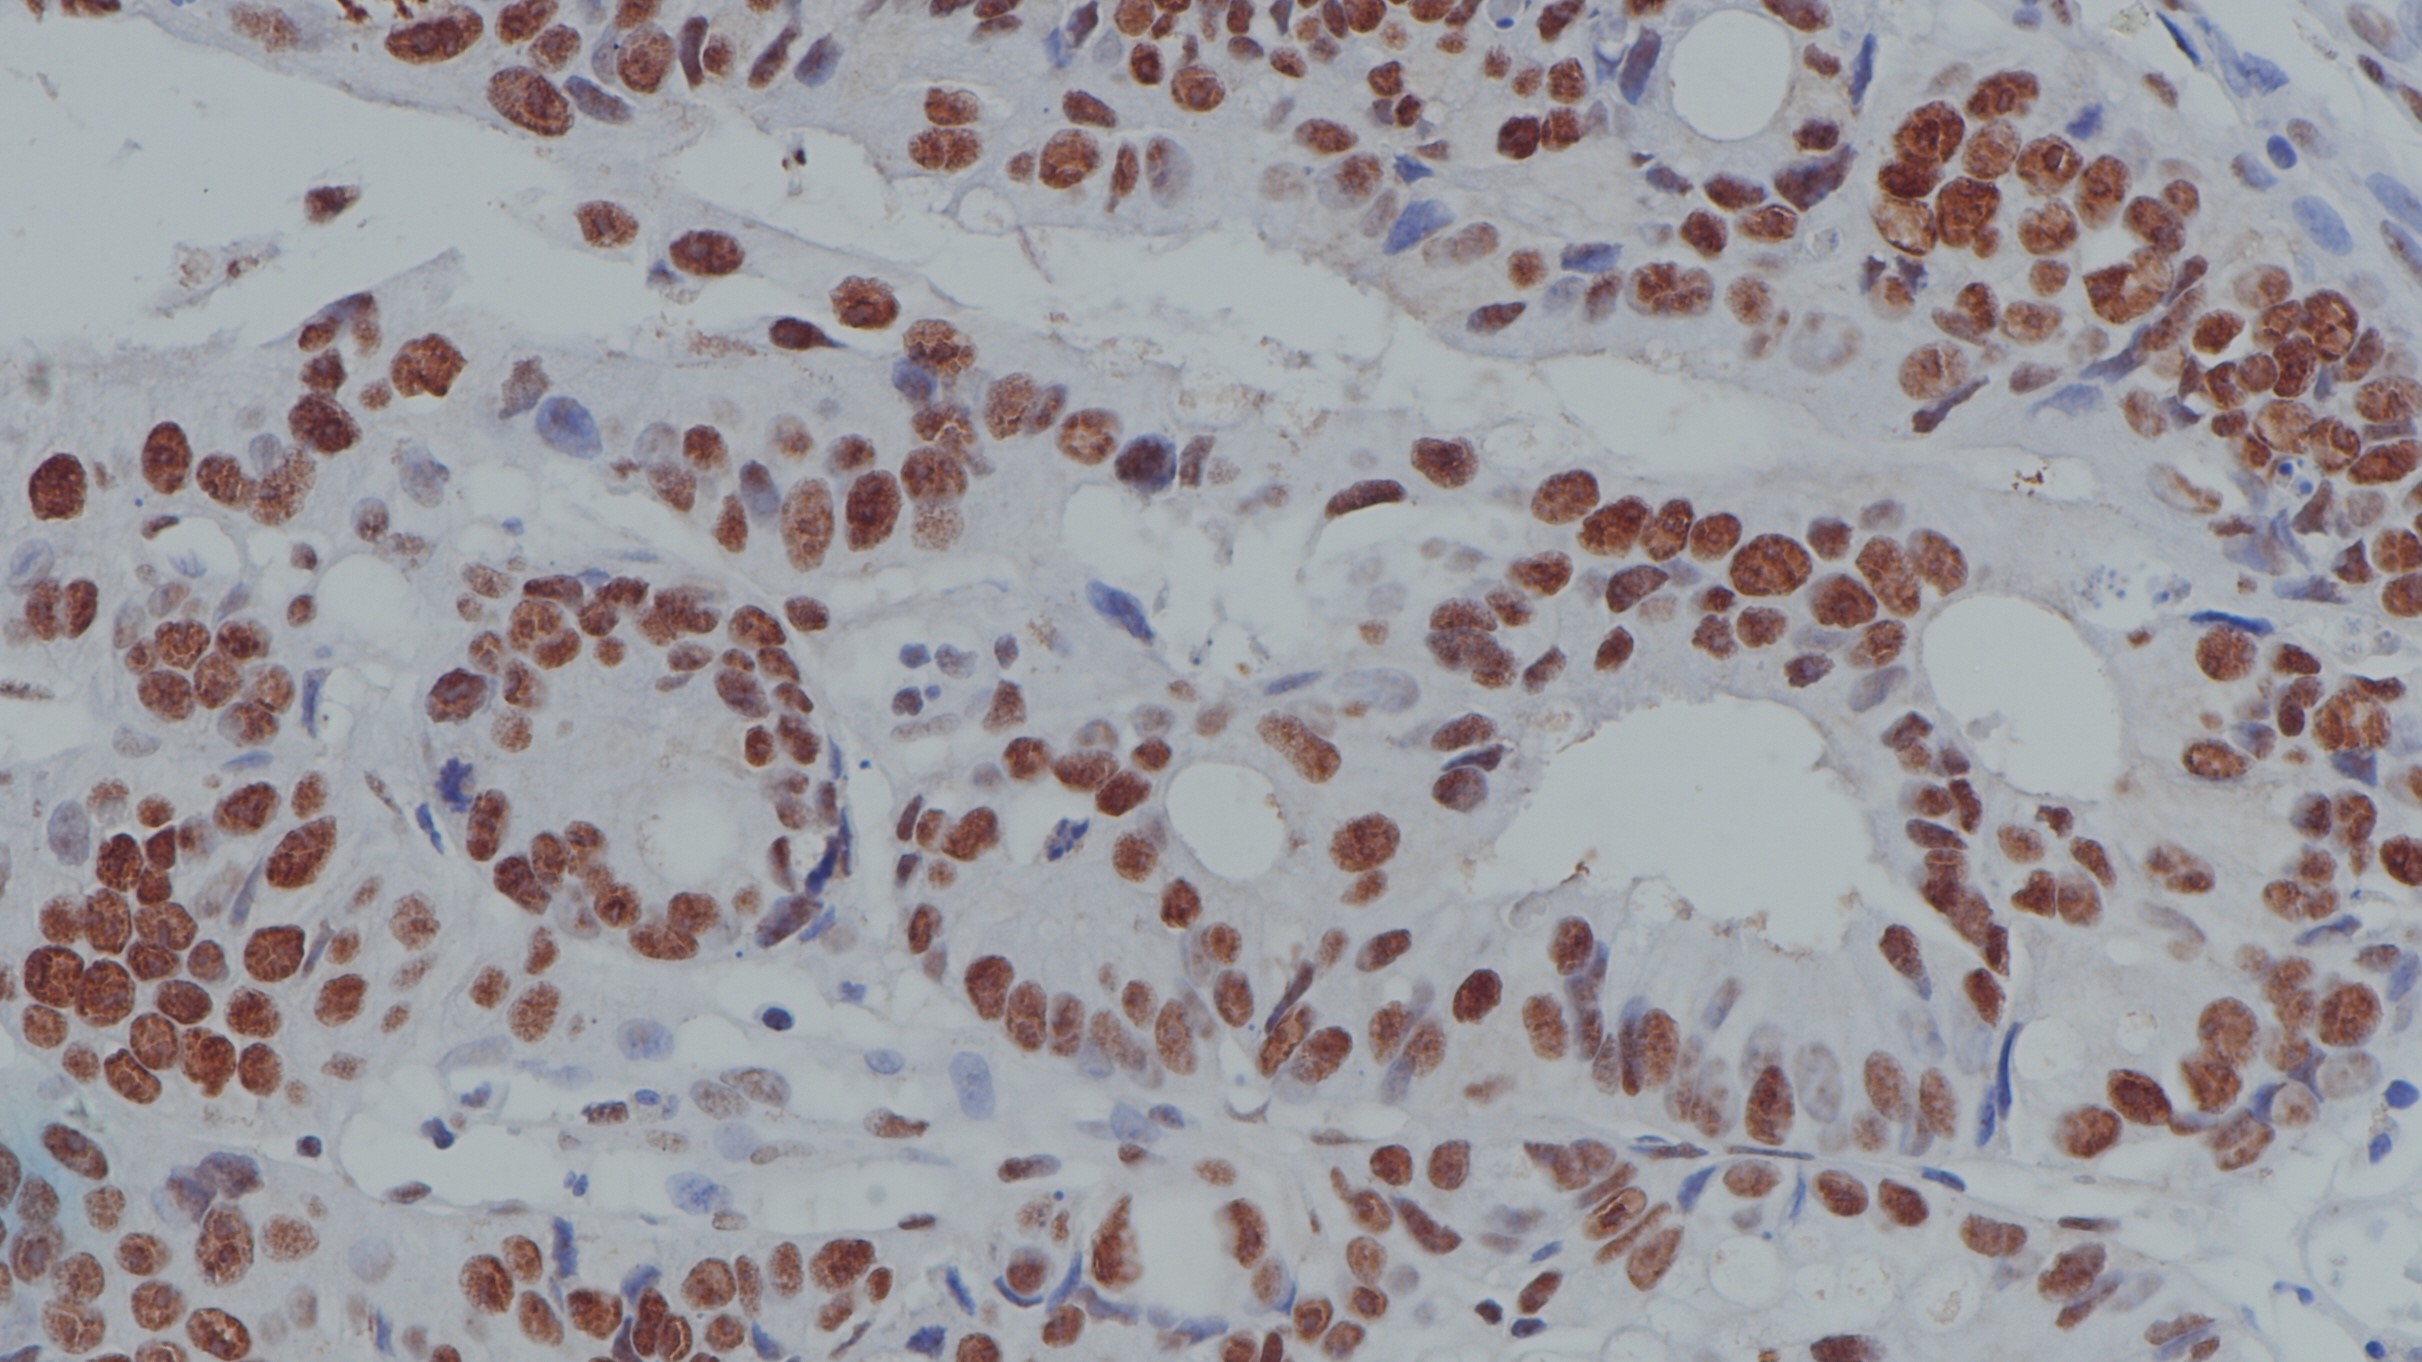
结肠癌MLH1(BPM6179)染色

1.Zhang Qingzhao,Young Gloria Q,Yang Zhaohai. Pure Discrete Punctate Nuclear Staining Pattern for MLH1 Protein Does Not Represent Intact Nuclear Expression.[J]. International journal of surgical pathology,2020,28(2).
2.钟璧璟,雷芹.结直肠癌患者MLH1、MSH2、MSH6、PMS2蛋白的表达水平及其与淋巴转移的相关性[J].海南医学,2020,31(03):287-290.
3.中华医学会.《临床技术操作规范·病理学分册》.人民军医出版社,2004.